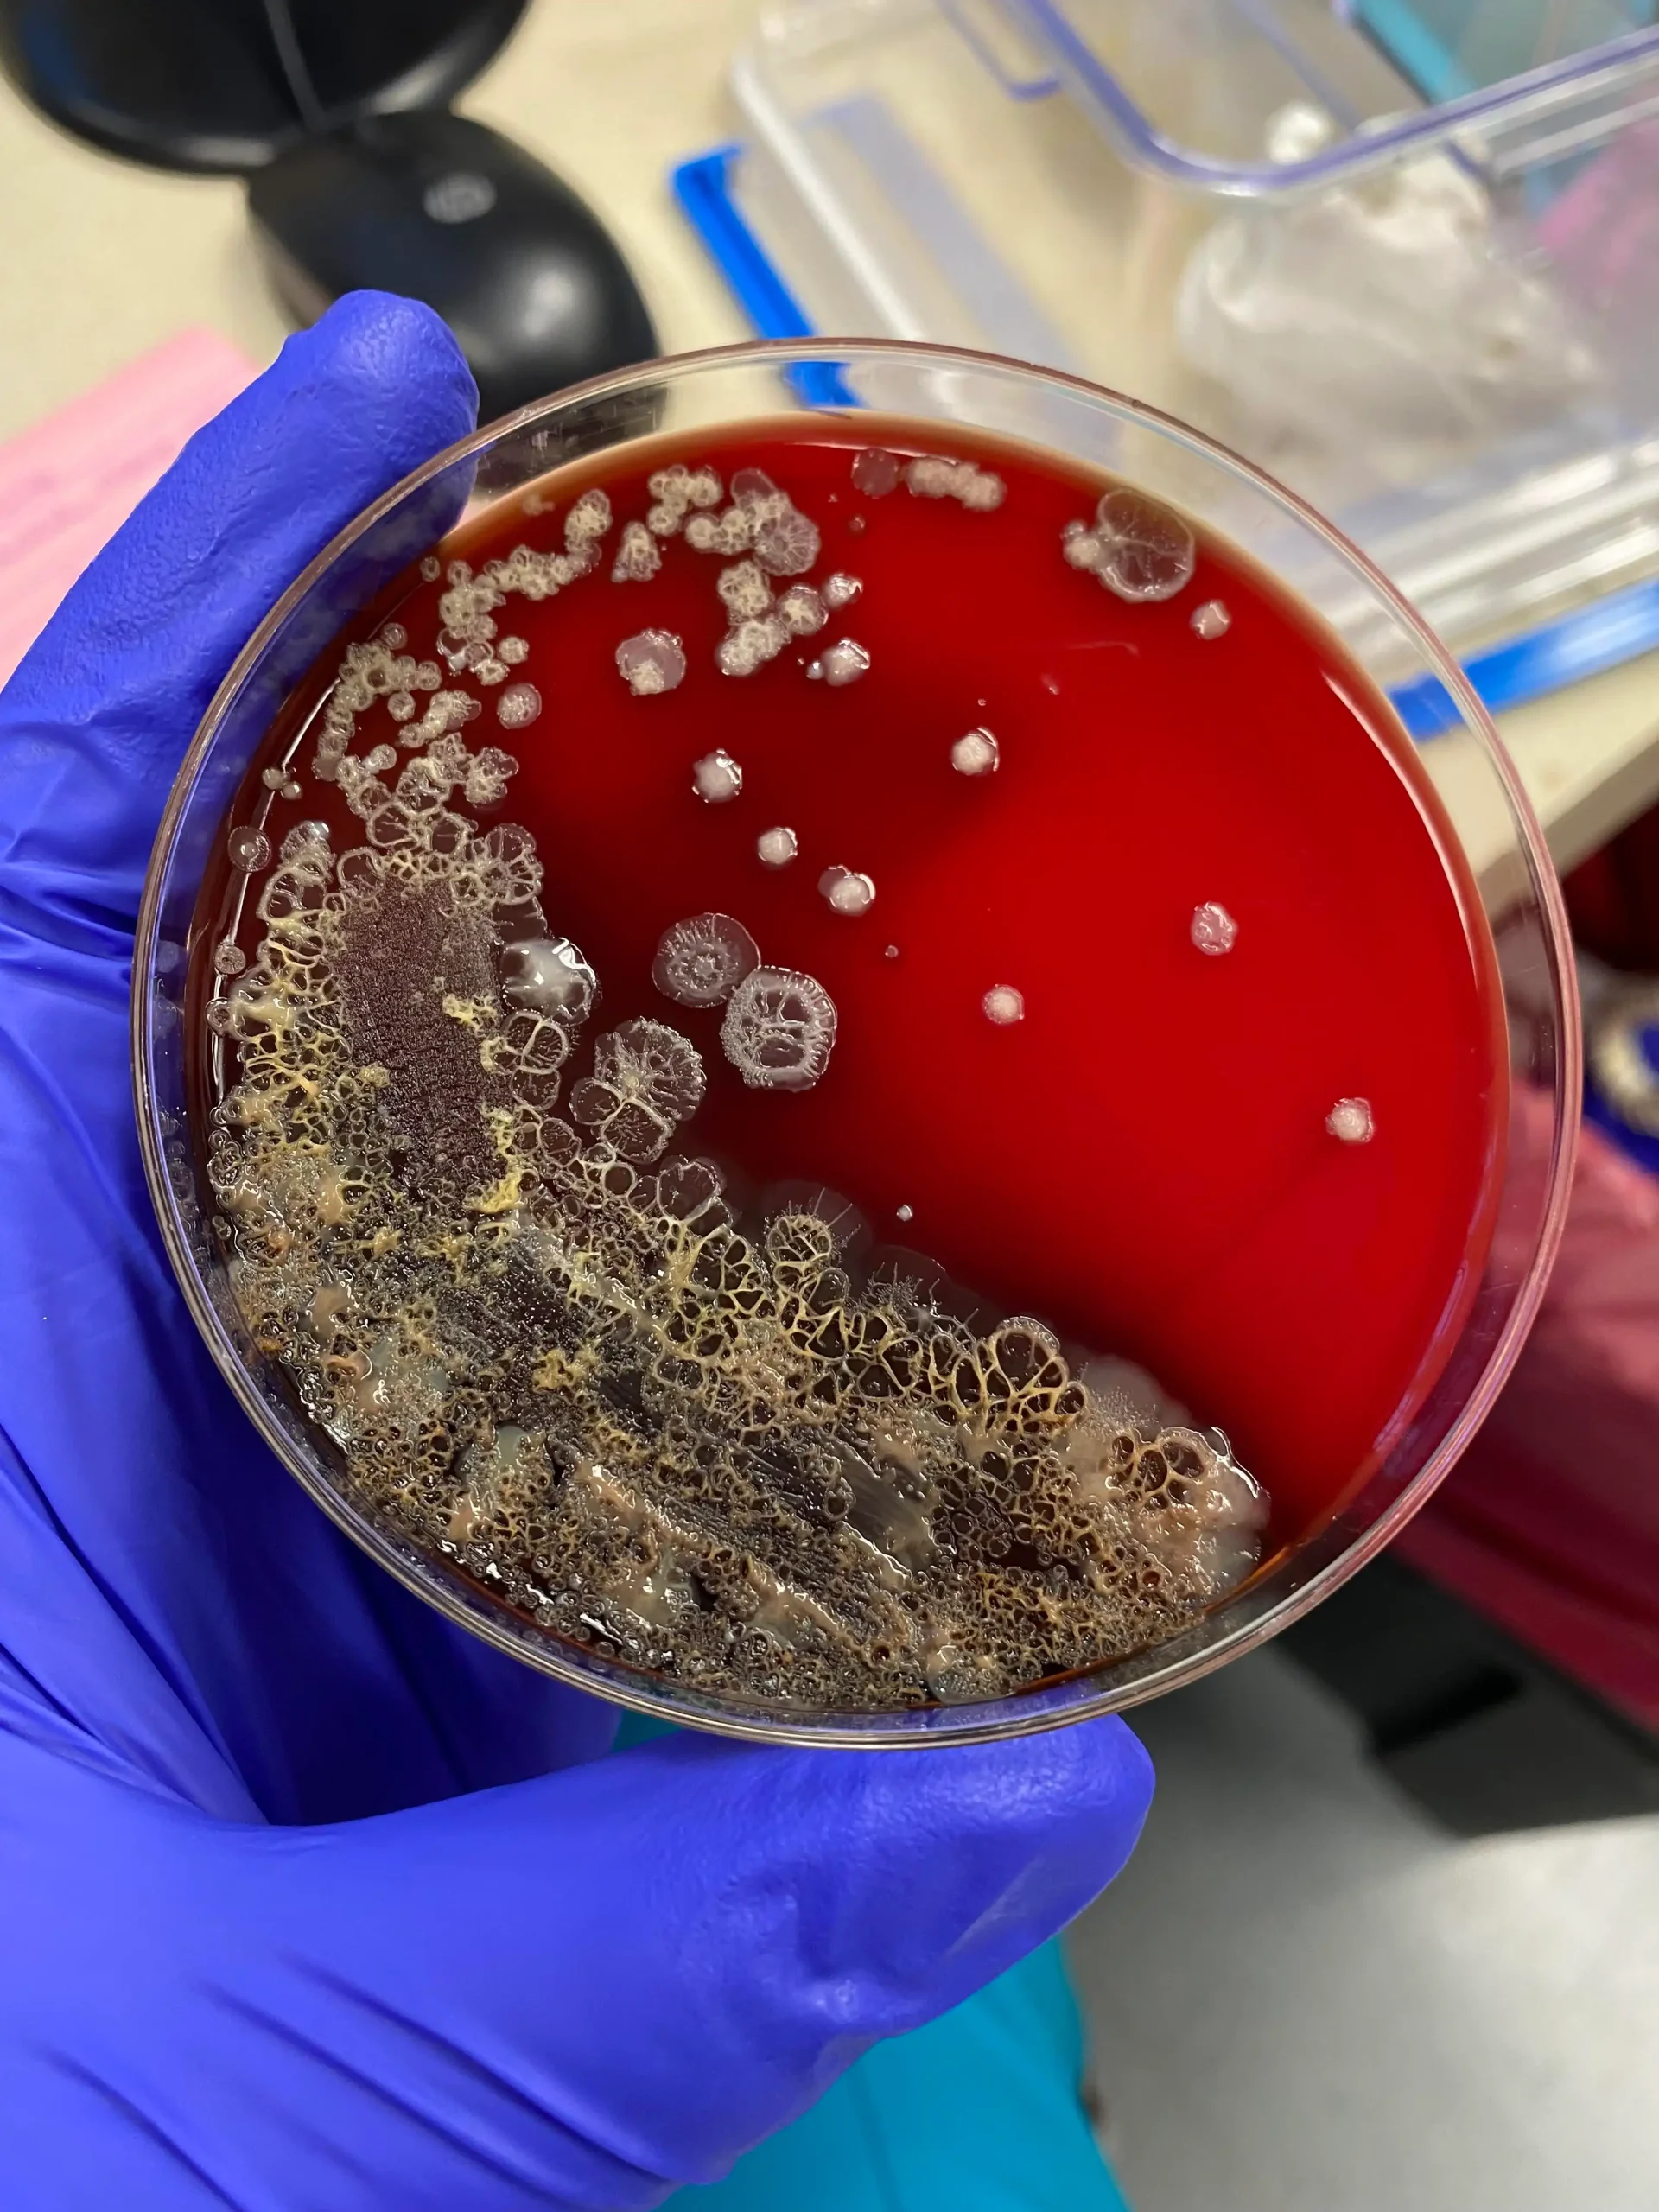
تفسیر نتایج آزمایش کشت مدفوع

فهرست مطالب
نمایش
مقدمهای بر آزمایش کشت مدفوع
آزمایش کشت مدفوع یکی از ابزارهای مهم در تشخیص بیماریهای گوارشی و عفونتهای مرتبط با دستگاه گوارش است. این آزمایشها میتوانند به شناسایی عوامل عفونی مانند باکتریها، ویروسها، و انگلها کمک کنند و همچنین اطلاعات مفیدی درباره وضعیت عملکردی دستگاه گوارش ارائه دهند. در این مقاله، فرآیند آزمایش کشت مدفوع، نحوهی تفسیر نتایج، و محدودیتهای آن بررسی میشود.
فرآیند آزمایش کشت مدفوع
۱-جمعآوری نمونه
کیفیت و دقت نتایج به روش صحیح جمعآوری نمونه بستگی دارد:
- روش صحیح جمعآوری:
- نمونه باید در ظرف استریل جمعآوری شود.
- از تماس نمونه با ادرار، آب، یا مواد شوینده جلوگیری شود.
- حفظ نمونه:
- در صورت تاخیر در انتقال نمونه به آزمایشگاه، باید آن را در دمای ۴ درجه سانتیگراد نگهداری کرد.
- برای تشخیص عوامل خاص (مانند ویروسها یا انگلها)، ممکن است نیاز به محیطهای نگهدارنده ویژه باشد.

۲- آزمایشهای اولیه مدفوع
- مشخصات فیزیکی:
- رنگ، قوام، و بوی مدفوع میتواند نشانهای از بیماری باشد.
- وجود خون، مخاط، یا چربی غیرطبیعی ممکن است نشاندهنده مشکلات گوارشی یا عفونت باشد.
- آزمایش شیمیایی:
- pH مدفوع: معمولاً بین ۶ تا ۷ است. تغییرات pH ممکن است نشاندهنده عدم تعادل میکروبی یا سوءجذب باشد.
- تست خون مخفی: برای شناسایی خونریزیهای غیرقابل مشاهده استفاده میشود.
- آزمایش میکروسکوپی:
- بررسی حضور گلبولهای سفید، تخم انگلها، یا کریستالهای چربی.
- وجود گلبولهای سفید میتواند به التهاب رودهای یا عفونت باکتریایی اشاره کند.
۳- کشت مدفوع
کشت مدفوع برای شناسایی عوامل عفونی خاص مانند باکتریها و قارچها انجام میشود:
- محیطهای کشت رایج:
- مککانکی آگار: برای شناسایی باکتریهای گرم منفی مانند Escherichia coli و Salmonella.
- Hektoen Enteric Agar: برای شناسایی Shigella و Salmonella.
- Campylobacter Agar: برای شناسایی Campylobacter jejuni.
- روش انجام کشت:
- نمونه به محیط کشت منتقل شده و در دمای مناسب (معمولاً ۳۷ درجه سانتیگراد) انکوبه میشود.
- پس از ۲۴ تا ۴۸ ساعت، کلونیهای رشد یافته بررسی میشوند.
۴- شناسایی عوامل بیماریزا
- باکتریهای شایع:
- Salmonella spp.: عامل تب تیفوئید و گاستروانتریت.
- Shigella spp.: عامل دیسانتری باکتریایی.
- Clostridioides difficile: عامل کولیت آنتیبیوتیک مرتبط.
- انگلها:
- بررسی وجود تخم، کیست، یا اشکال تروفوزوئیتی انگلها مانند Giardia lamblia و Entamoeba histolytica.
- ویروسها:
- روشهای مولکولی مانند PCR برای شناسایی ویروسهای روتاویروس و نوروویروس استفاده میشود.
۵- آزمایشهای تکمیلی
- آزمایش حساسیت آنتیبیوتیکی:
- برای تعیین حساسیت میکروارگانیسمها به آنتیبیوتیکهای مختلف.
- این آزمایش برای بهبود درمان بیماران ضروری است.
- آزمایشهای مولکولی:
- روشهای مدرن مانند PCR و NGS (Next Generation Sequencing) برای شناسایی عوامل بیماریزا با دقت بالا.
۶- تفسیر نتایج آزمایش کشت مدفوع
- نتایج مثبت:
- رشد میکروارگانیسمهای بیماریزا نشاندهنده وجود عفونت است.
- شناسایی گونههای مقاوم به آنتیبیوتیک ممکن است درمان را تحت تأثیر قرار دهد.
- نتایج منفی:
- عدم رشد عوامل بیماریزا ممکن است نشاندهنده عدم عفونت باشد، اما باید احتمال مصرف آنتیبیوتیک یا وجود عوامل غیرقابل کشت نیز در نظر گرفته شود.
- آلودگی نمونه:
- رشد میکروارگانیسمهای معمولی فلور روده ممکن است به دلیل آلودگی باشد.
۷- محدودیتها و مشکلات آزمایش کشت مدفوع
- زمانبر بودن: کشت مدفوع معمولاً ۲۴ تا ۴۸ ساعت زمان میبرد.
- آلودگی نمونه: روش نادرست جمعآوری یا نگهداری میتواند نتایج را تحت تأثیر قرار دهد.
- تشخیص ناقص: برخی عوامل بیماریزا ممکن است با روشهای استاندارد شناسایی نشوند.
همچنین بخوانید:
نویسنده: مهرداد ایزدی راد





